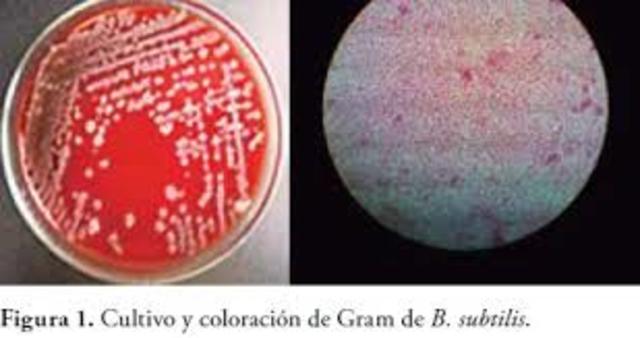
Bacillus Subtilis

-
APARECEN LOS TRATADOS DE LUCRENCIO EL CUEAL PROPUSO ENTRE EL AÑO 55 Y 95 A.C QUE LAS ENFERMEDADES ERAN OCACIONADOS POR ORGANIMOS O ORGANISMO INVISIBLES PARA EL OJO HUMANO E INDECTECTABLES PARA EL SER HUMANO CONVIRTIENDOLAS EN UN ENEMIGO ESCURRIDISO
-
Biólogo italiano. Fue profesor de historia natural en Pavía y director del Museo Mineralógico de esta ciudad. Considerado uno de los fundadores de la biología experimental, sus trabajos de investigación se centraron en los principales fenómenos vitales, como la respiración, la reproducción, la digestión, etc. Realizó importantes estudios sobre la reproducción artificial. Demostró la acción del jugo gástrico en el proceso digestivo y el intercambio de gases en la respiración.
-
Se inventa el microscopio por un fabricante de anteojos de origen holandés, llamado Zaccharias Janssen, alrededor del año 1590.
el cual permitio el estudio y profundizacion de la biologia -
El origen del microoscopio es una cuestión aún incierta. Se considera a Zacharias Janssen es el inventor del microoscopio compuesto de dos lentes.
Los primeros microscopios compuestos producidos por los Janssen eran simplemente un tubo de 45 cm de largo y 5 cm de diámetro con una lente convexa en cada extremo. Este instrumento llegó a tener entre 3 y 9 aumentos, dependiendo del tamaño de la abertura del diafragma. -
La microbiología es una ciencia muy nueva, aunque los organismos que estudia hayan sido los primeros en poblar la tierra. Hasta el siglo XVII no se empezó a suponer la existencia de microorganismos.
-
el inglés Robert Hooke creó el primer microscopio compuesto, en el cual se utilizaban dos sistemas de lentes, las lentes oculares (u ocular) para visualizar y las lentes objetivos.
luego de publicar el primer libro en el que se describían las observaciones de varios organismos realizadas a través de su microscopio. En su libro, Robert Hooke llamó a los numerosos compartimientos divididos por paredes “células”. El descubrimiento de las células provocó el rápido avance del microscopi -
En 1665 publicó el libro Micrographía, el relato de 50 observaciones microscópicas y telescópicas con detallados dibujos. Este libro contiene por primera vez la palabra célula y en él se apunta una explicación plausible acerca de los fósiles.
Hooke descubrió las células observando en el microscopio una lámina de corcho, dándose cuenta de que estaba formada por pequeñas cavidades poliédricas que recordaban a las celdillas de un panal. Por ello cada cavidad se llamó célula. -
publicó un libro titulado "Experienze in torno de la generazione deg'Insetti" en el que planteó un experimento sencillo pero contundente para refutar las creencias acerca de la aparición súbita y espontánea de los seres vivos. La preocupación de Redi era investigar el origen de los gusanos que aparecían en la carne en descomposición.
-
Comerciante holandés que se dedicó a pulir lentes y a observar todos los tejidos que iba construyendo. Estudió granos de polen, fluidos corporales, sarro de los dientes, y vio unas pequeñas estructuras que podían moverse y las llamó animáculos. La Royal Society entró en el asunto. Entonces surgió la pregunta siguiente, de donde provienen estos animáculos?
Por un lado están los partidarios partidarios de la generación espontanea, por otro lado están los partidarios de que parten de otros animácul -
Acaba con la idea de la generación espontánea (Experimento de Redi). Utiliza unos botes de cristal con trozos de carne, dichos botes los tapa con unas gasas que permiten el paso del aire pero de nada más, entonces no se generan "animáculos" en estos trozos de carne. La solución está en las larvas que son depositadas por moscas que se posaban en la carne, en los botes sin tapar, y hacían posible la aparición de esos "animáculos".
-
El calentamiento puede evitar la aparición de los animáculos, pero cuando aparecían era por el aire que entraba, por lo que se dedujo que estaban en el aire.
-
En el año de1796, Jenner registró los casos de viruela humana y animal e intuyó que la viruela del ganado podía dar inmunidad frente a la viruela humana clásica. Esta hipótesis tuvo su prueba cumbre en 1796, cuando en una epidemia de viruela Jenner logró extraer pequeñas gotas de pus de las pústulas presentes en una mujer campesina que había entrado en contacto con la viruela animal. Estas gotas fueron sembradas en el brazo de un niño y con ello se obtuvo, además de la cicatriz, la inmunidad
-
El 14 de mayo será por siempre una fecha memorable en la historia de las ciencias en general y del efecto preventivo de la vacuna en particular. Ese día del año 1796, El inglés Edward Jenner hizo la primera inoculación contra la viruela. James Phipps, un niño de ocho años de edad, fue el primer inoculado con secreción recogida de una pústula vacuna (viruela de vacas) en la mano de una lechera que se había infectado durante un ordeño. El primero de julio siguiente inoculó de nuevo al pequeño.
-
comienza a estudiar una dolencia que atacaba al Bombyx mori gusano de seda, o "mal de sueño", conocido actualmente como muscardina. La larva se cubría de un polvo blanco y moría, los cultivos prácticamente se abandonaron debido a su devastación.
-
En un artículo científico que leyó en la Sociedad Linneana (Londres) en 1831 y que publicó en 1833, Brown dio nombre al núcleo de las células eucariotas al organismo del centro que guardaba su material genetico
-
Bacillus subtilis es una bacteria Gram positiva, Catalasa-positiva, aerobio1 comúnmente encontrada en el suelo. Miembro del Género Bacillus, B. subtilis tiene la habilidad para formar una resistente endospora protectora, permitendo al organismo tolerar condiciones ambientalmente extremas.
-
Bassi demuestra que la muscardina era provocada por un cierto tipo de hongo que nombra Botrytis paradoxa (actual Beauveria bassiana), Describe la forma de eliminar y de prevenir aquel hongo lo que ayuda a la industria de la seda notablemente, Bassi publica los resultados de sus estudios y describe una teoría que explica numerosas dolencias vegetales, animales y de humanos por organismos patogénicos. Refuerza así, la teoría de que las enfermedades contagiosas como variola, tifo exantematico, síf
-
Lázaro Spallanzani comprobó que el tratamiento térmico repetido permitía evitar el crecimiento de microorganismos en infusiones. Supone un primer desarrollo de métodos de esterilización de líquidos.
-
Berkeley es considerado padre de la micología británica; llegando a describir muchísimas especies. Su herbario de cerca de 10 000 especies de champiñones (con alrededor de 5 000 que describe) se conservan en las colecciones de los Reales Jadines Botánicos de Kew.
Miles Joseph Berkeley descubre un hongo (Phytophthora infestans) que produce la podredumbre de la patata. -
Fue un médico húngaro que consiguió disminuir drásticamente la tasa de mortalidad en un 70 % por sepsis puerperal (una forma de fiebre puerperal) entre las mujeres que daban a luz en su hospital mediante la recomendación a los obstetras de que se lavaran las manos con una solución de cal clorurada antes de atender los partos. La comunidad científica de su época lo denostó y acabó falleciendo víctima de septicemia a los 47 años en un asilo. Algunos años después Luis Pasteur publicaría la hipótes
-
Demostró que el cólera era causado por el consumo de aguas contaminadas con materias fecales, al comprobar que los casos de esta enfermedad se agrupaban en las zonas donde el agua consumida estaba contaminada con heces, en la ciudad de Londres en el año de 1854. Ese año cartografió en un plano del distrito de Soho los pozos de agua, localizando como culpable el existente en Broad Street, en pleno corazón de la epidemia. Snow recomendó a la comunidad clausurar la bomba de agua, con lo que fueron
-
Mientras Louis Pasteur y Robert Koch son a menudo considerados los fundadores de la microbiología, su trabajo no reflejó fielmente la auténtica diversidad del mundo microbiano, dado su enfoque exclusivo en microorganismos de relevancia médica. Dicha diversidad no fue revelada hasta más tarde, con los trabajos de M. Beijerinck y S. Winogradsky.
Sergei Nikolaievich Winogradsky, nacido en Kiev, fué microbiólogo, ecologista y un científico ruso que inició el concepto de ciclo de la vida y descubrió -
Mientras Louis Pasteur y Robert Koch son a menudo considerados los fundadores de la microbiología, su trabajo no reflejó fielmente la auténtica diversidad del mundo microbiano, dado su enfoque exclusivo en microorganismos de relevancia médica. Dicha diversidad no fue revelada hasta más tarde, con los trabajos de M. Beijerinck y S. Winogradsky.
Sergei Nikolaievich Winogradsky, nacido en Kiev, fué microbiólogo, ecologista y un científico ruso que inició el concepto de ciclo de la vida y descubrió -
En el año 1864, a instancias del emperador Napoleón III, Pasteur investigó la causa por la que el vino y la cerveza se agriaban con el paso del tiempo, causando grandes pérdidas económicas a las empresas francesas debido a lo perecedero de estas mercancías. Pasteur regresó al pueblo de su infancia, Arbois, con el objetivo de resolver el problema definitivamente. Allí estudió el problema que afectaba a las viñas. Con ayuda de un microscopio, descubrió que, en realidad, intervenían dos tipos de o
-
GREGOR MENDEL DESCUBRE MEDIANTE ESPERIMENTOS CON CHICHAROS LAS LEYES DE LA HERENCIA EN EL ADN
Gregor Mendel trazó por primera vez los patrones hereditarios de ciertos rasgos en plantas de guisante y mostró que obedecían a reglas estadísticas sencillas. A pesar de que no todas las características muestran los patrones de la herencia mendeliana, su trabajo sirvió como prueba de que la aplicación de estadística a la herencia podía ser sumamente útil. -
omenzó a investigar una enfermedad que afectaba a la planta del tabaco, que se manifiesta por la formación de un extraño diseño con forma de mosaico sobre las hojas y a la que se refirió como “wildfire” (que significa “correr como la pólvora”), por la rapidez con la que se desarrollaba.
No podía encontrar el microorganismo causante de ello, lo mismo que tampoco Pasteur podía encontrar el de la rabia. Ivanovski sumergió unas hojas infectadas en un líquido para que se ablande e hizo pasar el espes -
Estudió el desarrollo del ciclo vital de diferentes protozoos y coronó la labor de su vida con el descubrimiento, en colaboración con Erich Hoffman, de la espiroqueta Treponema pallidum, agente productor de la sífilis.
Schaudinn fallece viajando de regreso a Alemania de un "Congreso Internacional de Medicina", en Lisboa, cuando debe ser intervenido quirúrgicamente de urgencia, por abcesos amebianos gastrointestinales. Tal infección amebiana muy probablemente haya sido voluntariamente adqu -
Fue un físico alemán que ganó el Premio Nobel de Física en 1986 por su trabajo en óptica electrónica, incluyendo el diseño del primer microscopio electrónico.
-
Un microscopio electrónico es aquél que utiliza electrones en lugar de fotones o luz visible para formar imágenes de objetos diminutos. Los microscopios electrónicos permiten alcanzar ampliaciones antes que los mejores microscopios ópticos, debido a que la longitud de onda de los electrones es mucho menor que la de los fotones "visibles". El primer microscopio electrónico fue diseñado por Ernst Ruska y Max Knoll entre 1925 y 1930, quienes se basaron en los estudios de Louis-Victor de Broglie ac
-
Médico y genetista. El "experimento de Griffith", que le hizo más famoso, tuvo lugar mientras investigaba una vacuna para prevenir la neumonía durante la pandemia de gripe que tuvo lugar tras la Primera Guerra Mundial. Para ello, usó dos cepas de la bacteria Streptococcus pneumoniae. La cepa S contenía una cápsula de polisacáridos y era virulenta al ser inyectada, causando neumonía y matando a las cobayas en un día o dos. Esta cápsula permitía a la bacteria resistir los ataques del sistema inmun
-
Alexander Fleming descubre la penicilina Las penicilinas son antibióticos del grupo de los betalactámicos empleados profusamente en el tratamiento de infecciones provocadas por bacterias sensibles. La mayoría de las penicilinas son derivados del ácido 6-aminopenicilánico, difiriendo entre sí según la sustitución en la cadena lateral de su grupo amino. La penicilina G o bencipenicilina fue el primer antibiótico empleado ampliamente en medicina; su descubrimiento ha sido atribuido a Alexander Flem
-
El descubrimiento en 1953 de la doble hélice, la estructura retorcida escalera de ácido desoxirribonucleico ADN Watson y Crick publicaron sus hallazgos en un artículo de una página, "Una estructura de ácido desoxirribonucleico," en el semanario científico británico el 25 de abril de 1953. La más importante de las "nuevas características" del "considerable interés biológico" que describieron era el emparejamiento de las bases en el interior de las dos cadenas principales de ADN: A = T y C = G.
-
Peter Piot viajó en 1976 hasta el norte del Congo para frenar una enfermedad entonces desconocida con una llamativa forma: excesivamente larga y con forma de cuerda, el virus llegó a Europa en un termo azul Nadie fue consciente de la peligrosidad del equipaje de mano que llevaba un mensajero en el vuelo desde Kinshasa, entonces Zaire, hasta Amberes, en 1976. Ni siquiera tenía idea de ello Peter Piot.
-
Allan Maxam y Walter Gilbert desarrollaron un método para secuenciar ADN basado en la modificación química del ADN y posterior escisión en bases específicas8 Aunque Maxam y Gilber publicaron su secuenciación química dos años antes del trascendental artículo de Sanger y Coulson
-
La clonación animal a partir de una célula adulta es mucho más difícil que de una célula embrionaria. Así pues, cuando los investigadores del Instituto Roslin de Escocia crearon a Dolly, único cordero nacido después de 277 intentos Para fabricar a Dolly, los investigadores usaron una célula de ubre de una oveja blanca de la raza Finn Dorset de seis años de edad. Tuvieron que encontrar un modo de 'reprogramar' las células de ubre para mantenerlas vivas sin que crecieran. Lo consiguieron altera
Want to make a timeline like this?
Use Timetoast to turn dates, events, milestones, and phases into a clear visual timeline you can build and share. Timetoast is a timeline maker for work, school, research, and stories.